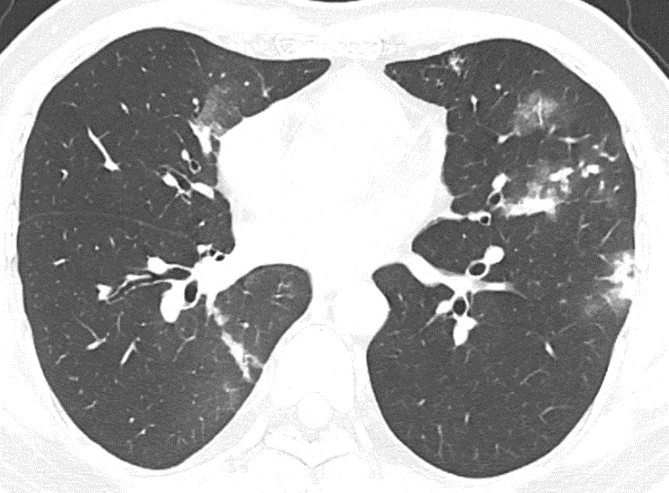
MEDLATEC 1.jpg

Ngạc nhiên nguyên nhân gây tổn thương phổi
Bệnh viện Đa khoa MEDLATEC vừa tiếp nhận nam bệnh nhân N.T.K (43 tuổi, ở Hà Nội) đến khám do khoảng 10 ngày nay có xuất hiện ho đờm xanh, tức ngực hai bên khi ho, cảm giác gai sốt về chiều, sụt 2kg và đã uống kháng sinh 7 ngày nhưng không đỡ.
Bệnh nhân cho biết thêm, gia đình có bố đẻ điều trị lao phổi năm 2019, còn bản thân 6 năm nay phát hiện mắc tiểu đường type 2, nhưng uống thuốc không đều và tự ý bỏ thuốc được 3 tháng.
Cách đây 7 tháng, anh có đi kiểm tra sức khỏe tại một cơ sở y tế có chẩn đoán theo dõi lao phổi. Do không xuất hiện triệu chứng ho, sốt nào nên anh K. chủ quan không xét nghiệm đờm làm chẩn đoán lao.
BSCKI. Phạm Sơn Tùng - Chuyên khoa Hô hấp, Bệnh viện Đa khoa MEDLATEC thăm khám và chỉ định anh K. làm xét nghiệm máu, chụp CT lồng ngực và làm các xét nghiệm vi sinh chuyên sâu.
Kết quả xét nghiệm có tăng bất thường chỉ số CRP - gợi ý cơ thể xuất hiện tình trạng viêm nhiễm cấp, xét nghiệm Glucose và HbA1c tăng cao.
Chụp CT lồng ngực kết luận hình ảnh đông đặc và nốt mờ hai phổi, có phá hủy tạo hang thùy trên phổi (theo dõi tổn thương do lao), hạch trung thất, thoái hóa cột sống ngực.
Đặc biệt, xét nghiệm vi sinh trên mẫu bệnh phẩm đờm có xét nghiệm Mycobacterium tuberculosis dương tính.
Sau khi có chẩn đoán xác định anh K. mắc viêm phổi - lao phổi AFB âm tính - đái tháo đường type 2 - viêm gan B mạn tính, BS. Tùng nhanh chóng hội chẩn cùng chuyên gia PGS.TS Hoàng Thị Phượng - nguyên Trưởng khoa Lao và Bệnh phổi - Viện Phổi Trung ương, đồng thời là chuyên gia cao cấp tại Hệ thống Y tế MEDLATEC.
Được chuyên gia tư vấn, ngay lập tức bệnh nhân nhập viện điều trị nội trú viêm phổi - lao phổi - đái tháo đường type 2 không kiểm soát.
PGS.TS Hoàng Thị Phượng chia sẻ: “Bệnh nhân K. đến MEDLATEC khám do vừa xuất hiện dấu hiệu cấp tính, dấu hiệu mạn tính và thêm triệu chứng viêm long đường hô hấp nên đặt ra vấn đề cần tầm soát bệnh lý cấp tính là hô hấp và bệnh lý nhiễm trùng là bệnh lý mạn tính. Hơn nữa, ở bệnh nhân này có bệnh nền, cộng với việc nghi ngờ mắc lao, dựa vào những yếu tố đó nên chúng tôi chỉ định bệnh nhân nhập viện điều trị nội trú”.
Những dấu hiệu cảnh báo nên sàng lọc lao phổi

Chuyên gia từ MEDLATEC cảnh báo, nên thực hiện tầm soát khi có những dấu hiệu nghi ngờ mắc lao phổi sau: Ho kéo dài trên 2 tuần (ho khan, ho đờm, ho ra máu); Gầy sụt cân, mệt mỏi; Sốt nhẹ về chiều, sốt kéo dài không rõ nguyên nhân trên 2 tuần, ra mồ hôi về đêm; Đau ngực, khó thở…; Triệu chứng viêm phổi cấp tính không đáp ứng với điều trị kháng sinh 2 tuần.
Bên cạnh đó, do bệnh lao phổi có tính chất truyền nhiễm nên cần sàng lọc lao cho người nhà bệnh nhân.

PGS.TS Hoàng Thị Phượng khuyến cáo, mắc lao phổi và bệnh tiểu đường là hai 2 tố cộng hưởng làm cho sức đề kháng bị giảm sút. Nên khi đã mắc tiểu đường, nếu không được kiểm soát sẽ thúc đẩy bệnh lao phổi tiến triển. Vì vậy, nếu mắc bệnh tiểu đường, để tránh biến chứng khôn lường cần kiểm tra đường huyết và tuân thủ nghiêm ngặt điều trị để tránh biến chứng.
Trường hợp bệnh nhân K., bên cạnh những yếu tố nguy cơ cao như gia đình có bố mắc bệnh lao, bản thân bệnh nhân trước đây đi khám có chẩn đoán lao phổi, có mắc tiểu đường nhưng lại tự ý bỏ thuốc điều trị. Nhưng may mắn bệnh nhân K. được phát hiện kịp thời, chính xác nên tăng cơ hội điều trị thành công.
Chẩn đoán lao phổi cần làm gì?
Để tránh bỏ sót bệnh, các trường hợp nghi ngờ mắc lao, BS. Tùng lưu ý chẩn đoán bệnh dựa trên các tiêu chuẩn sau:
Triệu chứng
Ho kéo dài trên hai tuần, gầy sụt cân, mệt mỏi, sốt nhẹ về chiều… nhưng cũng có một số trường hợp không có triệu chứng lâm sàng.
Xét nghiệm chẩn đoán lao ban đầu
Nhuộm soi trực tiếp tìm đờm AFB: Kỹ thuật nhuộm huỳnh quang. Nếu dương tính: phát hiện trực khuẩn kháng cồn kháng toan, cần làm xét nghiệm Gen Expert, MGIT để khẳng định mắc lao.

Xét nghiệm sinh học phân tử phát hiện lao nhanh: Xét nghiệm phát hiện lao đồng thời phát hiện tính kháng thuốc: Xpert MTB/RIF; Xpert MTB/RIF Ultra. Kết quả xét nghiệm dương tính là tiêu chuẩn “vàng” chẩn đoán.
Xét nghiệm nuôi cấy vi khuẩn lao: Ưu tiên nuôi cấy môi trường lỏng (BACTEC MGIT). Kết quả xét nghiệm dương tính là tiêu chuẩn “vàng” chẩn đoán.
BS. Tùng cho biết, hiện nay, bác sĩ lâm sàng ưu tiên sử dụng xét nghiệm sinh học phân tử phát hiện lao nhanh và kháng thuốc thay thế cho xét nghiệm nhuộm soi tìm AFB.
|
Hệ thống Y tế MEDLATEC hiện sở hữu đầy đủ năng lực vượt trội về quy tụ đội ngũ chuyên gia, bác sĩ chuyên khoa Hô hấp, Chẩn đoán hình ảnh… cùng hệ thống máy móc, thiết bị hiện đại của Trung tâm Chẩn đoán hình ảnh, Xét nghiệm, Giải phẫu bệnh. Hàng ngàn người dân đã đến đây thăm khám, điều trị hiệu quả bệnh lý hô hấp, bệnh lao phổi. Để được tư vấn, liên hệ hotline: 1900 56 56 56. |
(Nguồn: MEDLATEC)